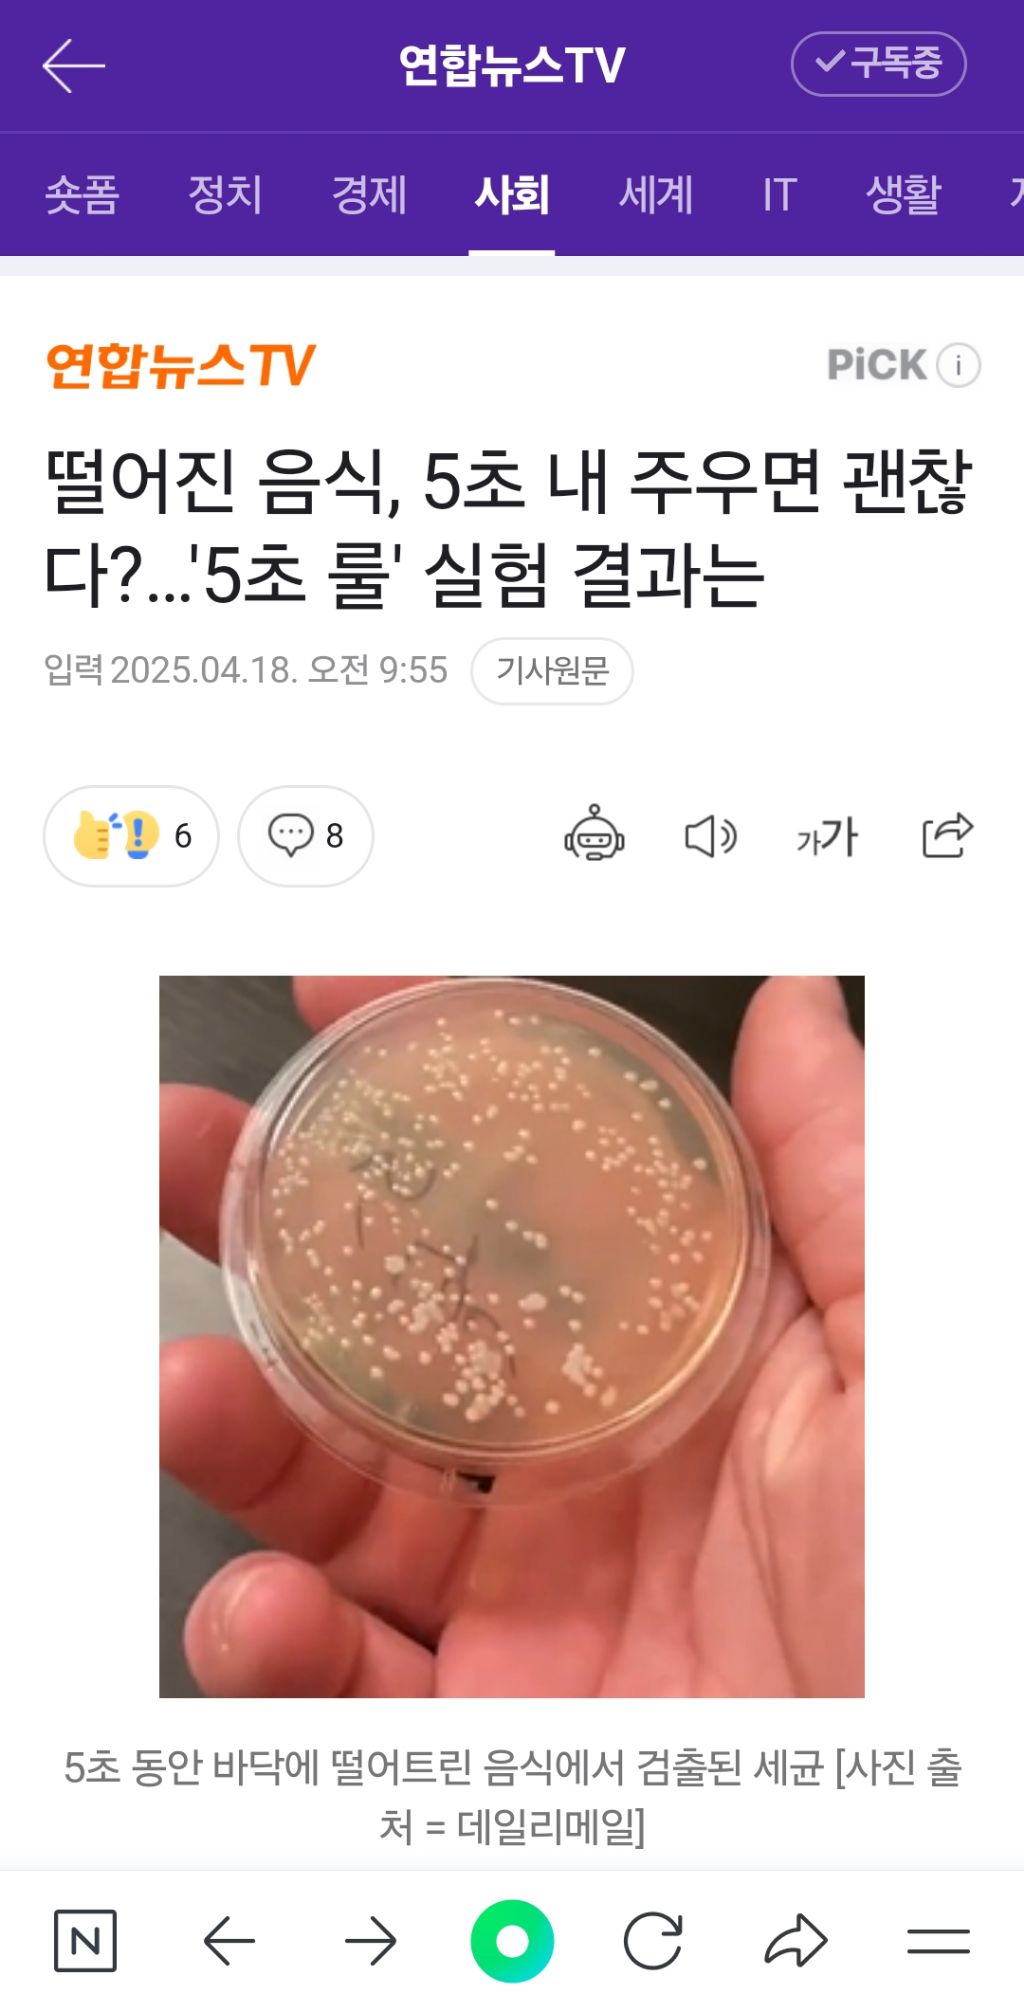

단축키
Prev이전 문서
Next다음 문서
단축키
Prev이전 문서
Next다음 문서
한 미생물학자가 음식을 떨어뜨려도 5초 안에 주우면 먹어도 괜찮다는 이른바 '5초 룰'이 실제 사실인지 실험을 통해 밝혀 눈길을 끌고 있습니다.
우리나라에서는 '3초 룰'로 통하는 식품 미신을 실제 검증해본 것입니다.
현지시간 16일 영국 데일리메일에 따르면 미국 시카고의 품질 관리 분석 책임자인 니콜라스 아이처는 음식물이 바닥에 떨어졌을 때 1초, 5초, 10초, 20초, 30초, 그리고 1분 동안 떨어진 상태로 놔둔 후 세균 증식을 측정한 결과를 공개했습니다.
아이처는 각각의 시간대에 맞춰 세균 배양 접시를 바닥에 놓고 일정 시간 동안 세균의 성장을 관찰했습니다.
실험 결과 모든 샘플에서 세균이 자라났고, 심지어 1초가 되지 않은 샘플에서도 세균 증식이 확인됐습니다.
1분간 바닥에 놓은 샘플이 5초 샘플과 비슷한 양의 세균을 보이자 아이처는 “5초든 60초든, 어차피 더럽다”고 설명했습니다.
실제로 바닥이나 일반적인 주방 표면은 살모넬라, 리스테리아 같은 박테리아가 가득할 수 있으며 음식이 닿는 즉시 오염될 수 있습니다.
해당 박테리아는 식중독의 주범으로, 독소를 배출하며 질병을 유발합니다.
살모넬라균은 장을 중심으로 치명적인 장티푸스를 유발할 수 있으며 뇌수막염 같은 심각한 합병증을 일으키고 심하면 사망에 이르게 합니다.
해당 실험 영상을 본 현지 누리꾼들은 "‘떨어진 음식은 먹지 않는다’는 단순한 원칙이 가장 안전한 선택"이 될 것 같다는 반응을 보였습니다.
#5초룰 #떨어진음식 #위생 #박테리아
↓ https://naver.me/5D8fHVzp
연합뉴스TV 기사문의 및 제보 : 카톡/라인 jebo23
김민서 ms3288@yna.co.kr
| 번호 | 분류 | 제목 | 날짜 | 조회 수 | 추천 수 |
|---|---|---|---|---|---|
| 공지 | 이슈 서브덕질 규칙 | 2024.10.05 | 4216 | 0 | |
| HOT글 | 이슈 | 이딴 걸 누가 사????????????? 5 | 2025.05.15 | 607 | 0 |
| HOT글 | 이슈 |
택시기사 숨졌는데 10대 가해자들, 병원서 춤추며 “X 같다”
5 |
2025.05.16 | 452 | 0 |
| HOT글 | 이슈 |
40살 히키코모리를 책임 지는 70살 부모 (스압+수정)
4 |
2025.05.17 | 151 | 0 |
| 공지 | 사랑LOVE 포인트 만렙! 도전 | 2025.03.19 | 4586 | 73 | |
| 공지 | 🚨(뉴비필독) 전체공지 & 포인트안내 2 | 2024.11.04 | 25842 | 54 | |
| 공지 | URL만 붙여넣으면 끝! 임베드 기능 | 2025.01.21 | 20425 | 43 | |
| 156990 | 이슈 |
돈복, 재물, 성공을 강조하는 교회가 사이비 이단인 이유
|
2025.05.18 | 52 | 0 |
| 156989 | 이슈 | 퀄리티 쩌는 이재명 후보 TV광고 | 2025.05.17 | 139 | 0 |
| 156988 | 이슈 |
40살 히키코모리를 책임 지는 70살 부모 (스압+수정)
4 |
2025.05.17 | 151 | 0 |
| 156987 | 이슈 |
북한 평양 지하철(지하철도) 모습
|
2025.05.17 | 146 | 0 |
| 156986 | 이슈 |
미묘한 번역의 세계
2 |
2025.05.17 | 133 | 0 |
| 156985 | 이슈 |
치약 연마제 함량 따른 ‘마모도’ 표기해야(이 시린여시는 쓰는 치약 마모도 확인하고가 p&g브렌닥스 암웨이 글리스터)
2 |
2025.05.17 | 140 | 0 |
| 156984 | 이슈 |
경상도 VS 전라도 찐 사투리 싸움
|
2025.05.17 | 136 | 0 |
| 156983 | 이슈 |
응답하라 시리즈 음식들
3 |
2025.05.17 | 130 | 0 |
| 156982 | 이슈 |
국짐에서 민주당 온 사람들이 하나같이 하는 말
2 |
2025.05.17 | 128 | 0 |
| 156981 | 이슈 |
커서 보면 대단하다고 느껴지는 악역 캐릭터
2 |
2025.05.17 | 139 | 0 |
| 156980 | 이슈 |
여성 화가들이라 그런지 색감 미감 죽여주지 않냐
|
2025.05.17 | 128 | 0 |
| 156979 | 이슈 |
엽기떡볶이(엽떡) 주문할 때 주의할 점
1 |
2025.05.17 | 135 | 0 |
| 156978 | 이슈 |
로또 1등 당첨판매점(명당X)
3 |
2025.05.17 | 146 | 0 |
| 156977 | 이슈 |
대법 “몰래 촬영한 성관계 영상, 지인 2명에게 보여준 것은 처벌 못해”
|
2025.05.17 | 147 | 0 |
| 156976 | 이슈 |
배우 수현 브이로그에 올라온 본인의 영어공부법.. (+ 반려견 두부)
|
2025.05.17 | 141 | 0 |
| 156975 | 이슈 |
길가던 여성이 취한 남성에게 다가간 이유
|
2025.05.17 | 161 | 0 |
| 156974 | 이슈 |
손흥민 협박한 남녀 커플 체포 사진
|
2025.05.17 | 161 | 0 |
| 156973 | 이슈 |
러닝으로 32kg 감량한 연예인 ㄷㄷㄷ
1 |
2025.05.17 | 142 | 0 |
| 156972 | 이슈 |
야가다 현장 외국인들의 고충
|
2025.05.17 | 168 | 0 |
| 156971 | 이슈 |
고대 그리스의 여자 노예 훈육법 ㄷㄷㄷㄷㄷㄷㄷ
1 |
2025.05.17 | 173 | 0 |
| 156970 | 이슈 |
국제결혼 집안에서 반대한다
|
2025.05.17 | 163 | 0 |
| 156969 | 이슈 |
[속보] 백악관, 미국 신용등급 하향 조정을 "거부한다"
|
2025.05.17 | 133 | 0 |
| 156968 | 이슈 |
꼰대보다 더 하다는 젊은 진상들 특징
|
2025.05.17 | 162 | 0 |
| 156967 | 이슈 |
많이 자란 쌈디 조카 채채 근황ㅋㅋ
|
2025.05.17 | 143 | 0 |
| 156966 | 이슈 |
국민의 혈세로 로고 바꾼 남양주시가 비난받지 않는 이유
|
2025.05.17 | 150 | 0 |
| 156965 | 이슈 |
중국 여자 팬의 초대를 받은 한국인 유튜버
|
2025.05.17 | 153 | 0 |
| 156964 | 이슈 |
결혼 안 한 30대 백수가 면접 보러 가면 생기는 일
|
2025.05.17 | 172 | 0 |
| 156963 | 이슈 |
고척돔 버튜버 공연
|
2025.05.17 | 157 | 0 |
| 156962 | 이슈 |
유명 강사가 말하는 재능
|
2025.05.17 | 152 | 0 |
| 156961 | 이슈 |
권진아가 대박날뻔한거 가로채갔다는 크러쉬
|
2025.05.17 | 160 | 0 |
